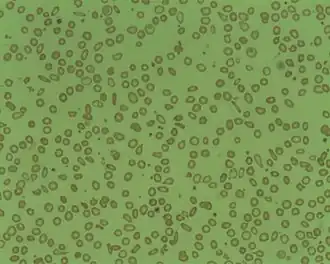
Description de l'image Microcytosis.jpg.

Anémie microcytaire
| Causes | Carence en fer des végétaux |
|---|---|
| Symptômes | Microcytose |
| Spécialité | Hématologie |
|---|
| CIM-10 | D50.8 |
|---|---|
| OMIM | 206200 |
| MeSH | C562385 |
![]() Mise en garde médicale
Mise en garde médicale
L'anémie microcytaire est l'un des nombreux types d' anémie caractérisée par de petits globules rouges (appelés microcytes). Le volume corpusculaire moyen normal (abrégé VCM ou souvent en anglais (MCV) sur les résultats de la numération globulaire totale) est de 80 à 100 fL, avec des cellules plus petites (<80 fL) décrites comme des cellules microcytaires et des cellules plus grandes (> 100 fL) comme macrocytaires (ces dernières surviennent dans l’anémie macrocytaire). Le VGM est la taille moyenne des globules rouges.
Dans l’anémie microcytaire, les globules rouges (érythrocytes) sont aussi généralement hypochromes , ce qui signifie que les globules rouges paraissent plus pâles que d’habitude. Cela se traduit par une concentration corpusculaire moyenne d'hémoglobine (souvent en anglais MCHC sur les feuilles de prises de sang) inférieure à la normale, une mesure représentant la quantité d'hémoglobine par unité de volume de liquide à l'intérieur de la cellule; normalement environ 320-360 g/L ou 32-36 g/dL. Par conséquent, l'anémie de cette catégorie est généralement appelée "anémie microcytaire hypochrome".
Les causes
Les causes typiques de l'anémie microcytaire incluent:
- Dans l'enfance
- L'anémie ferriprive[1] de loin la cause la plus courante d'anémie en général et d'anémie microcytaire en particulier
- Thalassémie
- A l'âge adulte
- Déficience en fer: après avoir éliminé une perte de sang évidente, comme dans la métrorragie, ou occulte (ulcère ou cancer digestif), il faut toujours penser à la possibilité d'une malabsorption intestinale, telle que dans la maladie cœliaque, trop souvent non diagnostiquée ou trop tardivement, en tout cas.
- Anémie sidéroblastique, Dans l'anémie sidéroblastique congénitale, le VCM (volume globulaire moyen) est faible ou normal. En revanche, le VCM est généralement élevé dans l'anémie sidéroblastique acquise, beaucoup plus courante.
- Anémie inflammatoire[2], bien que ceci provoque plus typiquement une anémie normochrome, normocytaire. L'anémie microcytaire a été discutée par Weng et al.[2]
- Empoisonnement au plomb
- Carence en vitamine B6 (pyridoxine)
Il faut également prendre en compte les autres causes généralement associées à une anémie normocytaire ou à une anémie macrocytaire , et la présence d'au moins deux causes d'anémie peut déformer le tableau typique.
L'anémie microcytaire est à l'origine de cinq causes principales, à savoir[3]:
Thalassémie, Anémie chronique, Carence en fer, Intoxication par le plomb et Anémie sidéroblastique congénitale.
Seuls les trois premiers sont communs dans la plupart des régions du monde. En théorie, ces trois peuvent être différenciés par leurs morphologies de globules rouges. L'anémie d'une maladie chronique montre des globules rouges non remarquables, une carence en fer montre une anisocytose , une anisochromie et une elliptocytose , et la thalessémie montre des cellules cibles (Target cells) et un pointillé basophile grossier. Dans la pratique, des elliptocytes et une anisocytose sont souvent observés dans la thalassémie et les cellules cibles présentent parfois une carence en fer[3]. Tous les trois peuvent montrer une morphologie des globules rouges sans particularité. Les pointillés basophiles grossiers sont une découverte morphologique fiable pour le diagnostic de la thalassémie, car ils ne se manifestent pas en cas de carence en fer ou d’anémie de maladie chronique. Le patient doit appartenir à un groupe ethnique à risque et le diagnostic ne sera pas confirmé sans une méthode de confirmation, telle qu'une CLHP (HPLC en anglais) pour l'hémoglobine, une coloration du corps en H, des tests moléculaires ou une autre méthode fiable. La formation de points basophiles se produit dans d’autres cas, comme indiqué dans le tableau 1 [3]
Voir également
Références
- ↑ « Molecular basis of inherited microcytic anemia due to defects in iron acquisition or heme synthesis », Haematologica, vol. 94, no 3, , p. 395–408 (PMID 19181781, PMCID 2649346, DOI 10.3324/haematol.13619, lire en ligne)
- 1 2 Weng, Chen JB, Wang J et Wu CC, « Surgically Curable Non-Iron Deficiency Microcytic Anemia: Castleman's Disease. », Onkologie, vol. 34, nos 8–9, , p. 456–8 (PMID 21934347, DOI 10.1159/000331283, lire en ligne)
- 1 2 3 Ford, « Red blood cell morphology », International Journal of Laboratory Hematology, vol. 35, no 3, , p. 351–357 (PMID 23480230, DOI 10.1111/ijlh.12082)
- Portail de la médecine
- Portail de la biologie cellulaire et moléculaire